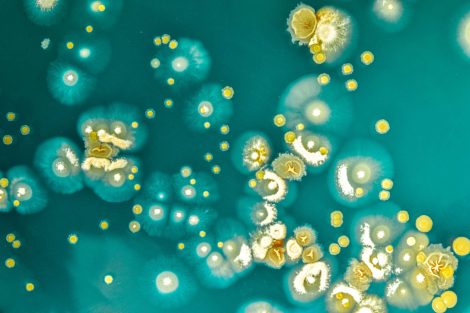

The use of antimicrobials in animals across the world has shown an overall decrease of 27%1 between 2016 and 2018, according to the data reported to the World Organisation for Animal Health (WOAH, founded as OIE).
Similar progress has been found in the use of antibiotics for growth promotion. For long a common way to enhance productivity in animals raised for human consumption, the use of antibiotics in healthy animals to boost growth is no longer a practice in nearly 70% of the reporting countries.

According to a landmark study published in The Lancet. However, the proportion of these deaths linked to antimicrobial resistance in animals still remains unclear. The phenomenon can originate in animal, human or plant populations, but then it poses a threat to all the other species. To curb it effectively, all sectors must join forces and encourage the prudent use of antimicrobials.
June 27, 2022/ WOAH.
https://www.woah.org